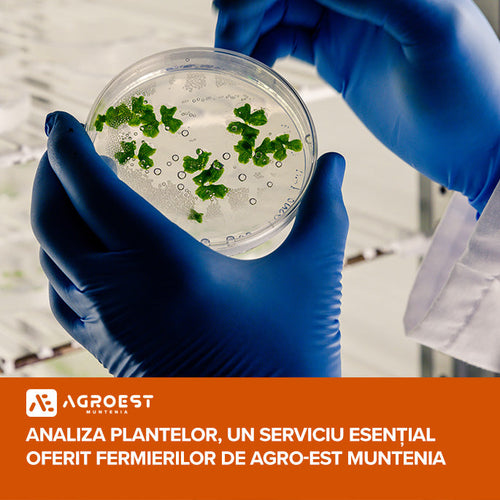

Blog
Postări recente
Apr 10, 2025
Fosfor disponibil, plante viguroase și sol mai eficient cu Ecofertil P, de la Agro-Est
Fosforul este un element esențial pentru dezvoltarea armonioasă a culturilor. Este implicat în procese fundamentale, precum formarea rădăcinilor,...
Citeste mai multMar 27, 2025
Nutrifort Cereal, de la Agro-Est Muntenia, corectează carențele de microelemente
Deficiențele de microelemente din culturile de cereale păioase pot avea un impact major în recoltele obținute de fermierii...
Citeste mai multMar 27, 2025
ZF Agropower. Mihai Moraru, fondator, Agro-EST Muntenia, centru de cercetare agricolă de 6 mil. euro la Buzău: Am vrut să facem un proiect de cercetare cu fermierii din România.
Dincolo de lipsa investiţiilor în cercetare din partea statului, nici mediul privat nu este mai deschis. Deşi se...
Citeste mai multMar 24, 2025
Rădăcini puternice și producții ridicate cu Nutrifort Starter, de la Agro-Est Muntenia
Startul bun al culturilor determină în mare parte succesul unei culturi și reușita unui an agricol. Plantele au...
Citeste mai multMar 24, 2025
Plantele mai puternice încep de la rădăcină – Folosește Nutrifort P40, de la Agro-Est Muntenia
Succesul unei culturi depinde de sănătatea și dezvoltarea sistemului radicular al plantelor. Pentru a le oferi fermierilor ajutor...
Citeste mai multMar 21, 2025
Analiza plantelor, un serviciu esențial oferit fermierilor de Agro-Est Muntenia
Profitul la final de an agricol depinde de producțiile obținute de fermieri. Pentru a avea producții ridicate cantitativ...
Citeste mai multMar 11, 2025
Agri Trade Summit: De la strategie la profit
Agri Trade Summit, eveniment de referință în agribusiness-ul românesc, și-a încheiat cu succes cea de-a treia ediție, care...
Citeste mai multOct 17, 2024
Stop risipei de Îngrășăminte!
În multe zone din țară, pe fondul precipitațiilor abundente, rapița este într-un stadiu vegetativ foarte dezvoltat și are...
Citeste mai multOct 16, 2024
Stop risipei de Îngrășăminte!
Deoarece încercăm să aducem în fața fermierilor soluții care să le maximizeze producțiile cu niște costuri mai mici,...
Citeste mai multSep 05, 2024
Fertilizanți și biostimulatori pentru următoarea cultură de grâu. Recomandări de la Agro-Est Muntenia
Compania Agro-Est Muntenia a dezvoltat o serie de recomandări pentru optimizarea tehnologiilor de fertilizare a grâului, în contextul...
Citeste mai multAug 07, 2024
Soiul de grâu Exotic: maturitate timpurie, rezistență la secetă și producții mari
SC Tea Consulting, condusă de Ioan Tudorel, produce și comercializează semințe de cereale de toamnă, în special sămânță...
Citeste mai multJul 17, 2024
“Agro-Est Muntenia”, o prezență cheie în industria inputurilor agricole
Timpul fermierului fiind foarte prețios, este esențial să știm din timp ce produse să aplicăm în momentul optim...
Citeste mai mult